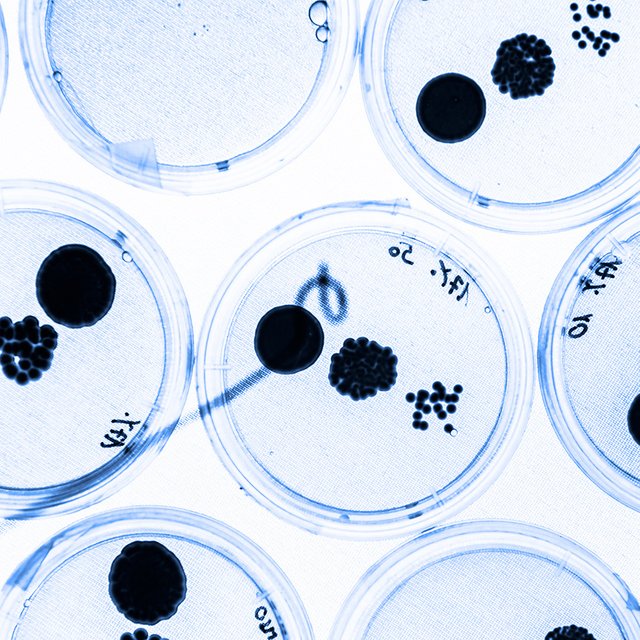
Новая инфекция из Китая? Что такое микоплазменная пневмония – в этом году ей стали массово болеть дети

Роспотребнадзор фиксирует рост заболеваемости внебольничной пневмонией, в том числе в школах и детсадах
В пресс-службе Роспотребнадзора РИА Новости подтвердили информацию о регистрируемом росте заболеваемости внебольничной пневмонией, в том числе в детских коллективах по всей стране. Ранее «Известия» сообщили о вспышках пневмонии в 16 регионах.
«Регистрируются групповые очаги в детских организованных коллективах. Основным возбудителем как в единичных случаях, так и в очагах, является микоплазма. Специалисты Роспотребнадзора заблаговременно, перед началом эпидемиологического сезона, приняли полный комплекс мер по недопущению осложнения обстановки по заболеваемости внебольничными пневмониями, поэтому ситуация контролируемая. В школах и детских садах усилено проведение утренних фильтров, в рамках которых проводится проверка на наличие симптомов болезни», — отмечают в пресс-службе.
По данным «Известий», подъем заболеваемости пневмонией наблюдается с середины октября в 16 российских регионах. Сложная ситуация наблюдается, например, в Коми, Удмуртии, Свердловской, Томской и Псковской областях.
Так, например, власти Пскова приняли решение о переводе с 21 октября всех школ муниципалитета на дистанционное обучение из-за роста числа внебольничных пневмоний среди учеников. Об этом сообщил ТАСС глава Пскова Борис Елкин. «С 21 октября все школы Пскова и переводятся на дистанционное обучение. Решение принято в связи с многочисленными случаями внебольничной пневмонии среди школьников. Напомню, что на сегодняшний день на карантин по предписаниям Роспотребнадзора закрыто пять школ города. Также приостанавливаются занятия в учреждениях дополнительного образования с 21 октября по 4 ноября, кружках культуры и спорта», –сказал Елкин.
По данным регионального управления Роспотребнадзора, за последнюю неделю в регионе выявлено 4 562 случая ОРВИ, показатель заболеваемости составил 77,61 на 10 тысяч населения. В городе Пскове зарегистрировано 2 235 случаев ОРВИ, или 49,% от общего количества по региону.
«На основании решения санитарно-противоэпидемической комиссии при администрации города Ханты-Мансийска с 16 октября по 25 октября 2024 года (включительно) реализация основных общеобразовательных программ для обучающихся 1-11-х классов всех 10 школ города, реализация программ дополнительного образования в муниципальных учреждениях будет осуществляться с применением электронных образовательных ресурсов — дистанционно», — сообщили ТАСС в администрации Ханты-Мансийска.
По данным регионального управления Роспотребнадзора, наибольшая заболеваемость ОРВИ в регионе отмечается среди детей от трех до шести лет. Заболеваемость COVID-19 относительно предыдущей недели повысилась до 8,1 случая на 100 тысяч населения, а внебольничными пневмониями — до 47,5 случая на 100 тысяч населения.
«Все случаи заболевания внебольничной пневмонии, в том числе в организованных коллективах активно расследуются, проводится комплексная лабораторная диагностика у заболевших и лиц, контактирующих с ними, организуются противоэпидемические мероприятия», — отметили в главном управлении Роспотребнадзора.
Madhourse / Shutterstock / Fotodom